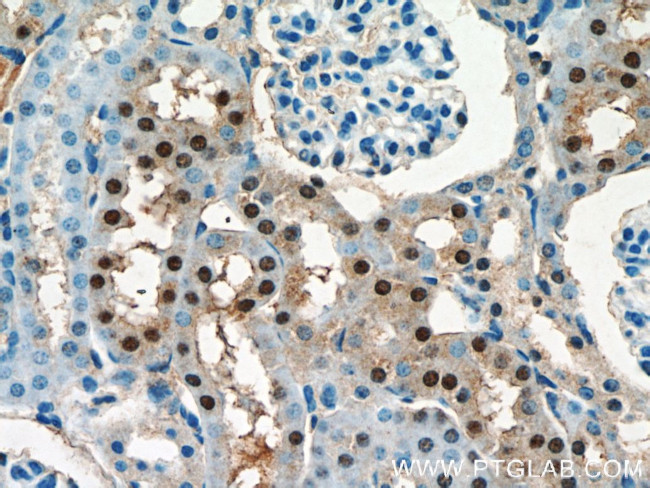
OTUD7B Antibody in Immunohistochemistry (Paraffin) (IHC (P))

Search
Proteintech
OTUD7B Polyclonal Antibody
{{$productOrderCtrl.translations['antibody.pdp.commerceCard.promotion.promotions']}}
{{$productOrderCtrl.translations['antibody.pdp.commerceCard.promotion.viewpromo']}}
{{$productOrderCtrl.translations['antibody.pdp.commerceCard.promotion.promocode']}}: {{promo.promoCode}} {{promo.promoTitle}} {{promo.promoDescription}}. {{$productOrderCtrl.translations['antibody.pdp.commerceCard.promotion.learnmore']}}
产品信息
16605-1-AP
种属反应
已发表种属
宿主/亚型
分类
类型
抗原
偶联物
形式
浓度
规格
纯化类型
保存液
内含物
保存条件
运输条件
产品详细信息
Immunogen sequence: MTLDMDAVL SDFVRSTGAE PGLARDLLEG KNWDVNAALS DFEQLRQVHA GNLPPSFSEG SGGSRTPEKG FSDREPTRPP RPILQRQDDI VQEKRLSRGI SHASSSIVSL ARSHVSSNGG GGGSNEHPLE MPICAFQLPD LTVYNEDFRS FIERDLIEQS MLVALEQAGR LNWWVSVDPT SQRLLPLATT GDGNCLLHAA SLGMWGFHDR DLMLRKALYA LMEKGVEKEA LKRRWRWQQT QQNEESGLVY TEDEWQKEWN ELIKLASSEP RMHLGTNGAN CGGVESSEEP VYESLEEFHV FVLAHVLRRP IVVVADTMLR DSGGEAFAPI PFGGIYLPLE VPASQCHRSP LVLAYD (1-355 aa encoded by B C020622)
靶标信息
Negative regulator of the non-canonical NF-kappa-B pathway that acts by mediating deubiquitination of TRAF3, an inhibitor of the NF-kappa-B pathway, thereby acting as a negative regulator of B-cell responses. In response to non-canonical NF-kappa-B stimuli, deubiquitinates 'Lys-48'-linked polyubiquitin chains of TRAF3, preventing TRAF3 proteolysis and over-activation of non-canonical NF-kappa-B. Negatively regulates mucosal immunity against infections. Deubiquitinates ZAP70, and thereby regulates T cell receptor (TCR) signaling that leads to the activation of NF-kappa-B (PubMed:26903241). Plays a role in T cell homeostasis and is required for normal T cell responses, including production of IFNG and IL2. Mediates deubiquitination of EGFR (PubMed:22179831). Has deubiquitinating activity toward 'Lys-11', 'Lys-48' and 'Lys-63'-linked polyubiquitin chains (PubMed:27732584). Has a much higher catalytic rate with 'Lys-11'-linked polyubiquitin chains (in vitro); however the physiological significance of these data are unsure (PubMed:27732584). Hydrolyzes both linear and branched forms of polyubiquitin. [UniProt]
仅用于科研。不用于诊断过程。未经明确授权不得转售。
生物信息学
蛋白别名: Cellular zinc finger anti-NF-kappa-B protein; cellular zinc finger anti-NF-kappaB Cezanne; Cezanne; OTU domain containing 7B; OTU domain-containing protein 7B; TRAF binding domain containing 2; unnamed protein product; Zinc finger A20 domain-containing protein 1; Zinc finger protein Cezanne; zinc finger, A20 domain containing 1
基因别名: 2900060B22Rik; 4930463P07Rik; AI462125; CEZANNE; OTUD7B; RGD1308111; Trabid2; ZA20D1
UniProt ID: (Human) Q6GQQ9, (Mouse) B2RUR8
Entrez Gene ID: (Human) 56957, (Rat) 310677, (Mouse) 229603